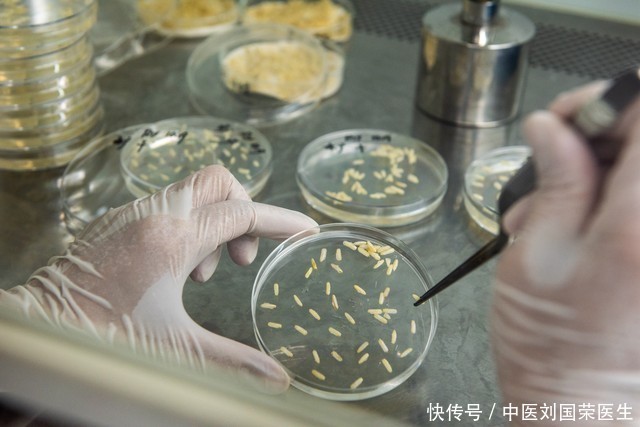

看到这里按天配资利息,你是不是也和李阿姨一样,觉得日常的食物存储方式可能隐藏着巨大的健康隐患?为什么看似健康的存储方式,会滋生如此可怕的黄曲霉素呢?这背后究竟有着怎样的科学原理?

黄曲霉素是一种毒性极强的剧毒物质,它的毒性是砒霜的68倍,是氰化钾的10倍,对肝脏组织的破坏性极强。世界卫生组织癌症研究机构将其划定为1类致癌物,摄入1毫克就可能致癌,一次性摄入20毫克就能致命。
临床数据显示,每年因食用被黄曲霉素污染的食物而导致中毒甚至患癌的案例不在少数。有研究机构对一些家庭的厨房进行抽样检测,发现不少家庭存储的花生、玉米、坚果等食物中,都检测出了不同程度的黄曲霉素。这些家庭中,很多都采用了类似李阿姨这样的存储方式,认为放在通风的地方就能保证食物安全。
实际上,像塑料桶这种密封性不好、材质也不适合长期存储食物的容器,在潮湿的环境下,很容易让食物受潮发霉。而黄曲霉素最喜欢在温暖潮湿的环境中生长繁殖,一旦食物发霉,就可能产生大量的黄曲霉素。
为了避免黄曲霉素的危害,我们应该改变这种看似健康实则危险的存储方式。可以将食物存放在密封性好的玻璃罐或陶瓷罐中,放在干燥、阴凉、通风的地方。同时,定期检查食物的状态,一旦发现有发霉的迹象,要立即丢弃,千万不要因为舍不得而继续食用。

健康无小事按天配资利息,食物存储方式更是关乎我们和家人的身体健康。赶紧检查一下你家的食物存储方式,别再让黄曲霉素有可乘之机了!
鸿阈配资提示:文章来自网络,不代表本站观点。